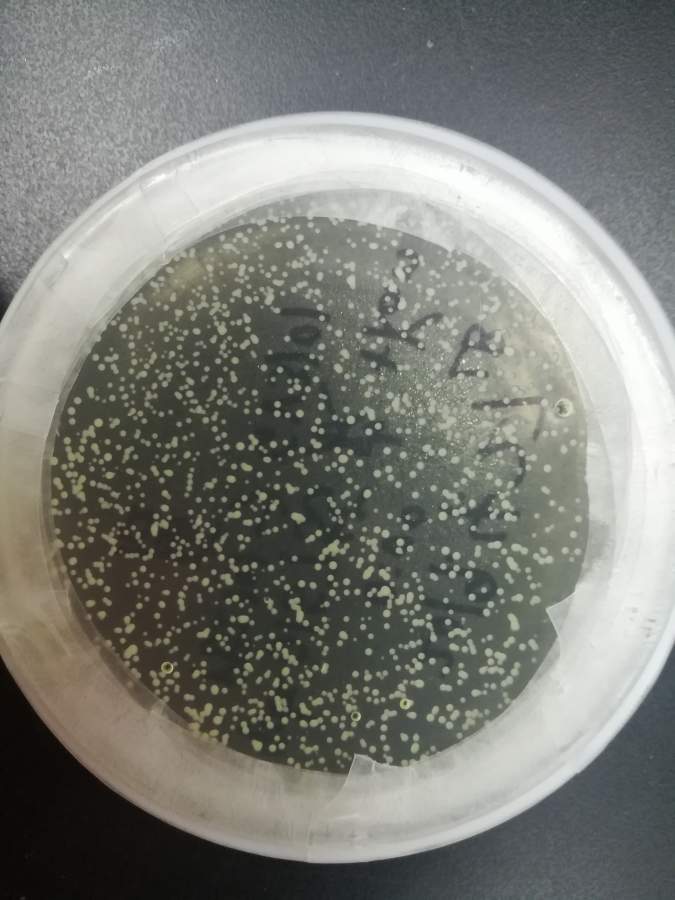
gv3101农杆菌感受态细胞转化
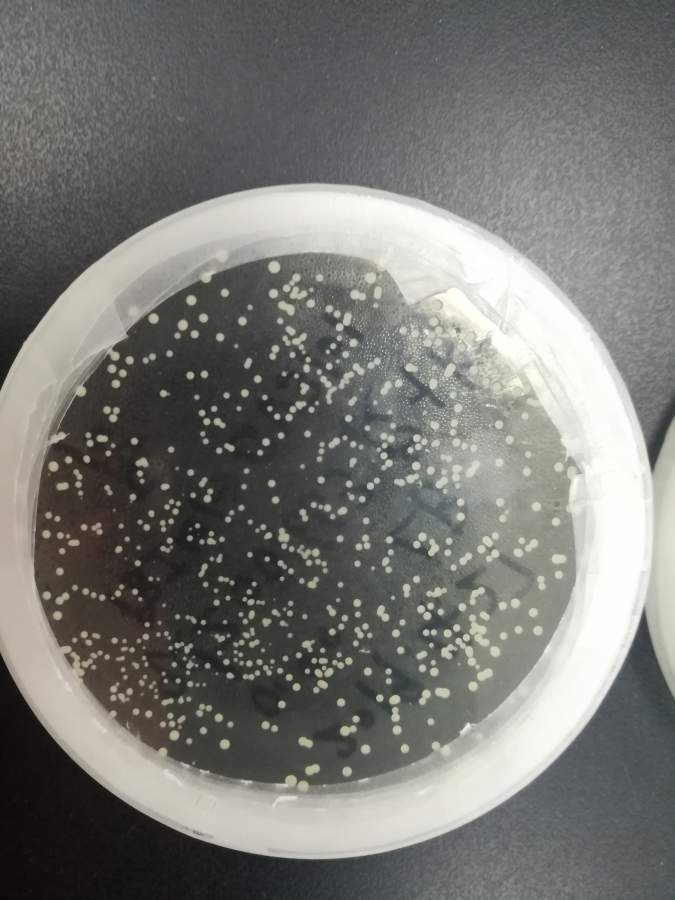
gv3101农杆菌感受态细胞转化

农杆菌

农杆菌(其他生物相关)_技点百科_技点网(其他生物相关)
图片尺寸1200x900
先从农杆菌谈起
图片尺寸560x396
农杆菌——基因转移的好手
图片尺寸640x480
农杆菌属
图片尺寸900x1200
分子生物学实验之农杆菌侵染拟南芥
图片尺寸1080x809
gv3101农杆菌感受态细胞转化
图片尺寸675x900
gv3101农杆菌感受态细胞转化
图片尺寸675x900
eha105农杆菌感受态细胞的应用
图片尺寸447x447
发根农杆菌ar msu440用于玉米烟草茶树青蒿等ty培养基活化试管菌
图片尺寸800x800
农杆菌转化法为什么通过大肠杆菌扩增基因?
图片尺寸1200x900
杆菌图片
图片尺寸525x350
不同方法转化大肠杆菌和农杆菌转化效率的研究
图片尺寸906x549
微生物的纯培养
图片尺寸330x287
dh5α感受态细胞
图片尺寸594x800
一种高效降解氨基甲酸乙酯的农杆菌及其应用
图片尺寸945x945
我侵染用的菌是直接吸取甘油保存的农杆菌摇菌的,是不是这个的原因?
图片尺寸1688x1392
"魔高一尺,道高一丈",植物防御根瘤农杆菌的分子机制
图片尺寸731x424
一种根癌农杆菌介导的平菇菌丝遗传转化方法与流程
图片尺寸991x1000
农杆菌t-dna整合到植物基因组的原理ppt
图片尺寸1080x810
2015年高考生物二轮复习 热点专练 基因工程与细胞工程(含解析)
图片尺寸1118x248